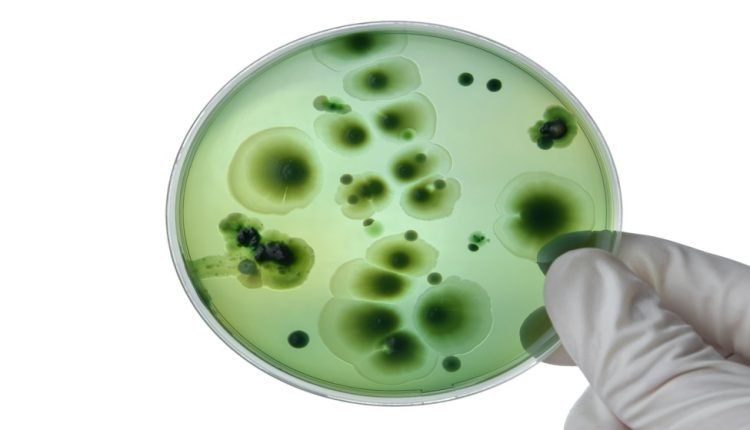

ضبط مواد غذائية غير صالحة للاستهلاك بالكرك
حصادنيوز – ضبطت بلدية الكرك الكبرى الاثنين، كميات من المواد الغذائية منتهية الصلاحية وغير الصالحة للاستهلاك البشري بسبب سوء التخزين.
وقال رئيس البلدية محمد المعايطة إن القسم الصحي في البلدية نفذ منذ بداية شهر أيلول الحالي حوالي 78 جولة رقابية على فترتين مسائية وصباحية تخللها تحرير 50 مخالفة، مؤكدا اتخاذ البلدية الإجراءات القانونية في أي مخالفة تصل إليها أو يرصدها القسم الصحي.
بدوره، أوضح رئيس القسم الصحي سند الحوراني، أن المخالفات تضمنت عرضا لمواد غذائية منتهية الصلاحية ومكشوفة، وبسطات معيقة لحركة المرور، إلى جانب محال دواجن ومخالفات صحية ورخص مهن.
بترا

التعليقات مغلقة.